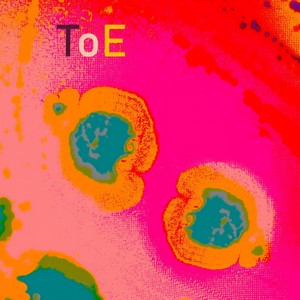
Toe - Glitching Sliders

您现在听到的是来自三原慧悟的歌曲《Greatest Story - 三原慧悟&吴小明》,如果觉得好听,分享给您的朋友一起来听吧!
温馨提示:本站不存储任何音频,版权均属于各音乐门户,如果无意侵犯了你的权益请通过底部联系我们!
他们在听
-
三原慧悟 04:52
-
Vapor 03:18
-
Alexandre Henri 01:54
-
Priesthood 03:57
-
Rohan Houssein 02:46
-
Mindscape 00:57
-
M Ali 02:32
-
M-291 04:00
-
眉儿 04:07
-
Jcostello 03:12
-
Toe 06:53
-
M-291 03:55
-
広川恵一 02:23
-
Malik Malo 03:23
-
Gregori Klosman 05:25
-
Loader 05:40
-
Los Chimeno 04:30
-
Tronus 05:46
-
Boycott Ent. 03:47
-
涵十六 03:07
-
Orso 03:26
-
ZayTooLit 01:58
-
Eple Trio 06:31
-
Telem 02:53
-
Eghoza 03:17
热门歌单
推荐音乐
-
我期待的不是你 2.69 MB 02:56
-
刘雨昕 3.63 MB 03:57
-
小梁的(梁思琪) 2.8 MB 03:03
-
我期待的不是你 3.87 MB 04:13
-
欧阳宏 2.77 MB 03:01
-
司司 3.15 MB 03:26
-
Bobo博official 2.21 MB 02:24
-
Eddie Chen 1.46 MB 01:35




![Vapor - Follow You Follow Me[Lily & The Snowman by Cineplex]](https://y.gtimg.cn/music/photo_new/T002R300x300M000004Wz3E822KtHk_1.jpg)